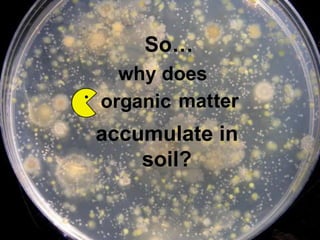
accumulate in
soil?
why does
matorganic ter
So…

The document discusses soil organic matter (SOM), its importance, and the impacts of agricultural practices on SOM levels. It describes the composition and functions of SOM, the balance between organic matter addition and decomposition, and various factors influencing SOM dynamics. Additionally, it highlights the effects of tillage, drainage, and management practices on soil health and organic matter accumulation.